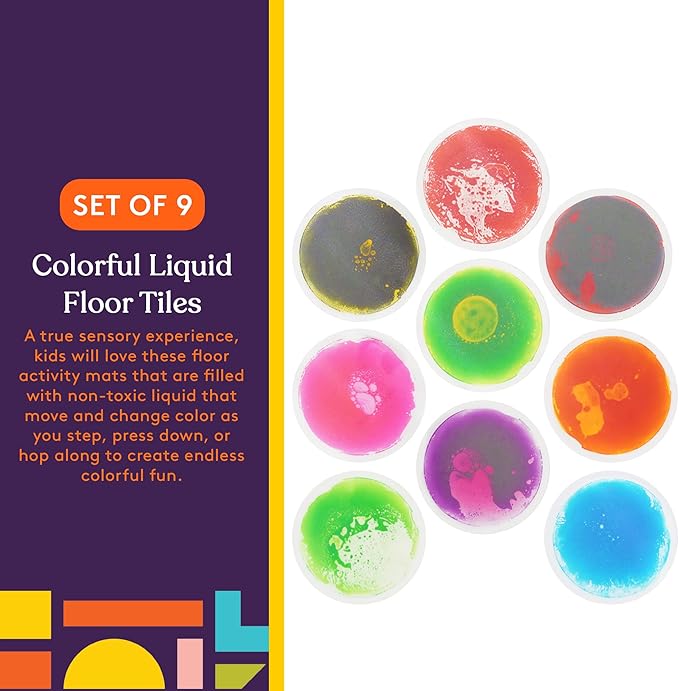

SpecialSupplies
Special Supplies Circle Floor Liquid Tiles for Kids, Set of 9, Colorful Early Learning Activity Mats for Toddlers and Children, Anti-Slip Backing for Active Play, Dance, and Games
Special Supplies Circle Floor Liquid Tiles for Kids, Set of 9, Colorful Early Learning Activity Mats for Toddlers and Children, Anti-Slip Backing for Active Play, Dance, and Games
Couldn't load pickup availability
About This
- Colorful Liquid Floor Tiles – A true sensory experience, kids will love these floor activity mats that are filled with non-toxic liquid that move and change color as you step, press down, or hop along to create endless colorful fun.
- Dance, Play, and Learn – These liquid-encased sensory tiles are tear and leak resistant to hold up against playing games, dancing around, and hopping and boast a non-slip backing to ensues they stay in place during play.
- Home and Classroom Use – Our floor activity mat tiles don’t require installation and can be placed down in a nursery for teaching colors, used by teachers to get kids in the right spots, creating interactive games or just having fun with friends.
- Durable and Skid-Resistant – We made our impact-resistant liquid floor tiles stronger and more resilient than standard activity floor mats to ensure they’re safer for babies and toddlers and support the weight of full-grown adults.
- Exciting Sensory Play – Liquid tiles can go in a bedroom, kitchen, living room, or even a doctor’s office to help keep kids focused, engaged, and stress free. There’s also no installation required so you can move them anywhere with ease.
Share

Reviews
Shop Now-
⭐️⭐️⭐️⭐️⭐️
This toy is an absolute hit in our backyard! The rockets fly so high, and it keeps my kids running and laughing for hours. Great quality and super easy to use.
Daniel H. -
⭐️⭐️⭐️⭐️⭐️
My kids are obsessed with this bug vacuum! It makes outdoor play so much more exciting and educational. The light-up habitat is such a fun bonus.
Rachel D. -
⭐️⭐️⭐️⭐️⭐️
My son can’t get enough of these buildable trucks! The electric drill is easy to use, and it keeps him focused and learning through play. Such a perfect STEM toy.
Lauren K.
Blog & Tips
View all-
The Science Behind Building Blocks: Why Kids Lo...
IntroFew toys are as timeless as building blocks. From wooden cubes to colorful LEGO sets, children across generations have been drawn to the joy of stacking, connecting, and building. But...
The Science Behind Building Blocks: Why Kids Lo...
IntroFew toys are as timeless as building blocks. From wooden cubes to colorful LEGO sets, children across generations have been drawn to the joy of stacking, connecting, and building. But...
-
“Tips for Buying Your Child’s First Toy”
Intro Buying your child’s very first toy is exciting—but it can also feel overwhelming. “What’s right for their age?” “Is it safe?” “Will they lose interest too quickly?” This guide...
“Tips for Buying Your Child’s First Toy”
Intro Buying your child’s very first toy is exciting—but it can also feel overwhelming. “What’s right for their age?” “Is it safe?” “Will they lose interest too quickly?” This guide...
-
Outdoor Play: How Movement Shapes Growing Minds
Introduction When children run, jump, and play outdoors, they are doing more than just burning off energy. Outdoor play builds stronger bodies, sharper minds, and happier hearts. From climbing trees...
Outdoor Play: How Movement Shapes Growing Minds
Introduction When children run, jump, and play outdoors, they are doing more than just burning off energy. Outdoor play builds stronger bodies, sharper minds, and happier hearts. From climbing trees...